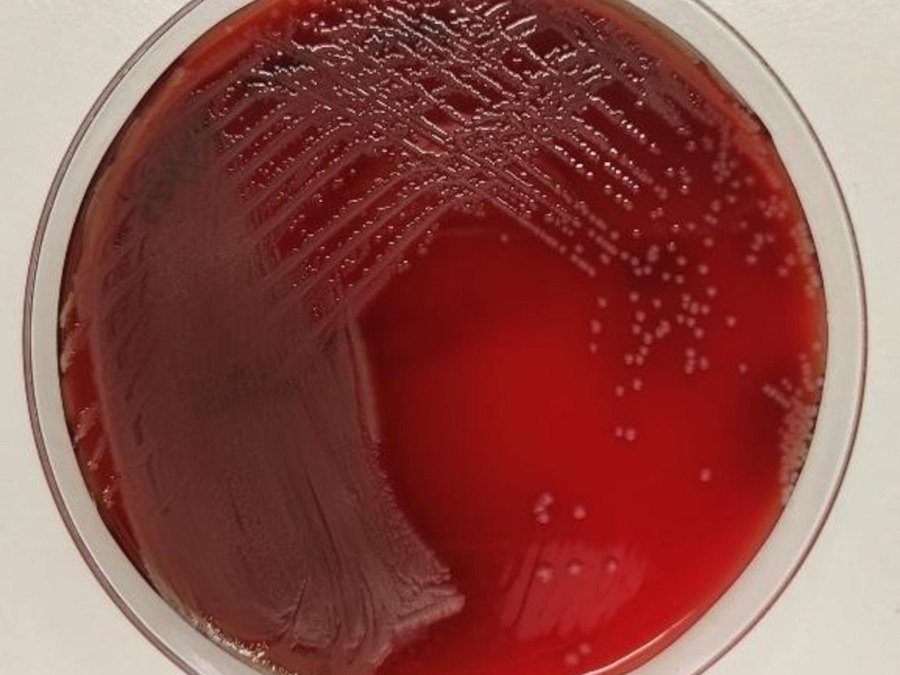
P.aeruginosa (Isabel M Barceló)

Las benzodiacepinas se utilizan para sedar a pacientes conectados a un respirador. No obstante, la ventilación mecánica aumenta drásticamente el riesgo de sufrir neumonía. ¿Podrían estos fármacos actuar sobre las bacterias causantes de infección, facilitando que causen la enfermedad? Una investigación con la bacteria P. aeruginosa describe cómo, en presencia de benzodiacepinas, este patógeno pasa de ser altamente agresivo a optar por un estilo de vida más pacífico o “silencioso”, diseminándose sin ser detectado, hasta que ya es demasiado tarde para evitar la infección.
Las benzodiacepinas como el diazepam o el midazolam son fármacos que se administran frecuentemente en la práctica clínica para sedar a los pacientes intubados y sometidos a ventilación mecánica. Existen varios estudios que sugieren que utilizar estos fármacos en lugar de otros sedantes aumenta el riesgo de que estos pacientes sufran neumonía bacteriana asociada a la ventilación, una infección grave y con altas tasas de mortalidad, sobre todo debido a que las benzodiacepinas pueden alterar la respuesta inmune del enfermo.
Algunos fármacos, además de actuar sobre el paciente, pueden también afectar la biología de algunos patógenos. Partiendo de esa idea nos planteamos la posibilidad de que las benzodiacepinas, al entrar en contacto con bacterias patógenas, pudiesen de algún modo afectar su comportamiento para tener más éxito en la infección de los pacientes intubados.
Reducir la virulencia para aumentar la supervivencia de la bacteria
Para corroborar nuestra hipótesis, escogimos una de las principales bacterias causantes de neumonía bacteriana asociada a la ventilación, Pseudomonas aeruginosa (dado que especies próximas parecen ser capaces de interaccionar con las benzodiacepinas), y analizamos cómo respondía a la exposición a estos fármacos.
Sabemos que la bacteria P. aeruginosa es capaz de atacar las células humanas accediendo a su interior, causar su muerte mediante la producción de toxinas, o ambas. Además, al entrar en contacto con las bacterias, las células humanas emiten señales inflamatorias que actúan como alarma para poner en marcha el sistema inmune. No obstante, al analizar dichos parámetros en presencia de benzodiacepinas observamos un efecto más bien contrario, es decir, se atenuó significativamente la capacidad de P. aeruginosa para invadir y matar las células humanas, así como para causar una respuesta inflamatoria potente.
Estos resultados sugieren que P. aeruginosa podría perder virulencia al exponerse a las benzodiacepinas, con lo cual la respuesta inmune sería también menor, lo que aumentaría las probabilidades de supervivencia de la bacteria, al menos en las primeras fases de establecimiento de la neumonía asociada a ventilación.
Biopelículas bacterianas más robustas
Por otro lado, quisimos comprobar la idea de que las benzodiacepinas pudiesen actuar fomentando la formación de biopelículas en P. aeruginosa. Una biopelícula es una comunidad de bacterias ancladas a una superficie e inmersas en una matriz extracelular formada por polisacáridos, ADN y proteínas, donde los patógenos se encuentran protegidos del sistema inmune y los antibióticos. Se sabe que ciertas bacterias pueden formar biopelículas en el tubo endotraqueal, la cánula que se usa para intubar a los pacientes ventilados, lo que les permite permanecer a salvo de los ataques inmunitarios y antibióticos, actuando además como reservorio que libera bacterias hacia las vías respiratorias inferiores, con efectos obvios para el desarrollo de neumonía bacteriana asociada a la ventilación.
En nuestro estudio comprobamos que, efectivamente, la bacteria P. aeruginosa tratada con benzodiacepinas formaba biopelículas más robustas (aproximadamente el doble de robustas que las formadas por bacterias no tratadas), que albergaban un número más elevado de bacterias vivas, tanto sobre plástico, como sobre secciones de tubos endotraqueales.
Por último, observamos que P. aeruginosa expuesta al fármaco midazolam experimentaba cambios significativos en la expresión de genes y rutas relacionadas con la formación de biopelículas, y también se incrementaba la acumulación de un mensajero químico clave en la formación de estas comunidades, etiquetado científicamente como c-di-GMP.
Sustituir las benzodiacepinas por otros sedantes
En resumen, nuestros resultados muestran cómo aparentemente las benzodiacepinas actúan sobre la bacteria P. aeruginosa facilitando que se comporte como un patógeno silencioso, lo que le permite pasar desapercibida hasta que es demasiado tarde para que el sistema inmune la elimine. Además, la formación de unas biopelículas más robustas, asociada a estos fármacos, generaría potentes reservorios de bacteria, a salvo de los antibióticos, que podrían favorecer el progreso de la neumonía en pacientes ventilados.
Todo ello resalta la importancia de desarrollar nuevos materiales para la fabricación de tubos endotraqueales resistentes a la formación de biopelículas, evitando que las bacterias patógenas se alojen allí. En definitiva, nuestros datos sugieren que la sustitución de las benzodiacepinas por otros sedantes podría ser beneficiosa para reducir el riesgo de neumonía asociada a la ventilación por P. aeruginosa en pacientes intubados.
Referencia:
Barceló, I.M., Jordana-Lluch, E., Escobar-Salom, M. et al. Analyzing the effects of benzodiazepines on the virulence and biofilm formation of Pseudomonas aeruginosa. Sci Rep 16, 2923 (2026). https://doi.org/10.1038/s41598-025-32848-4
Autores del artículo divulgativo:
Isabel María Barceló Munar, Elena Jordana Lluch, María Escobar Salom, Jordi Sansó Sastre, Antonio Oliver Palomo y Carlos Juan Nicolau
Institut d’Investigació Sanitària de les Illes Balears (IdISBa)
Fuente: Scientias
Artículo bajo licencia Creative Commons – Atribución (CC BY 4.0). Este artículo puede ser reproducido íntegramente siempre y cuando vaya firmado por los autores y se acredite SCIENTIAS como fuente, incluyendo el enlace a nuestra página.